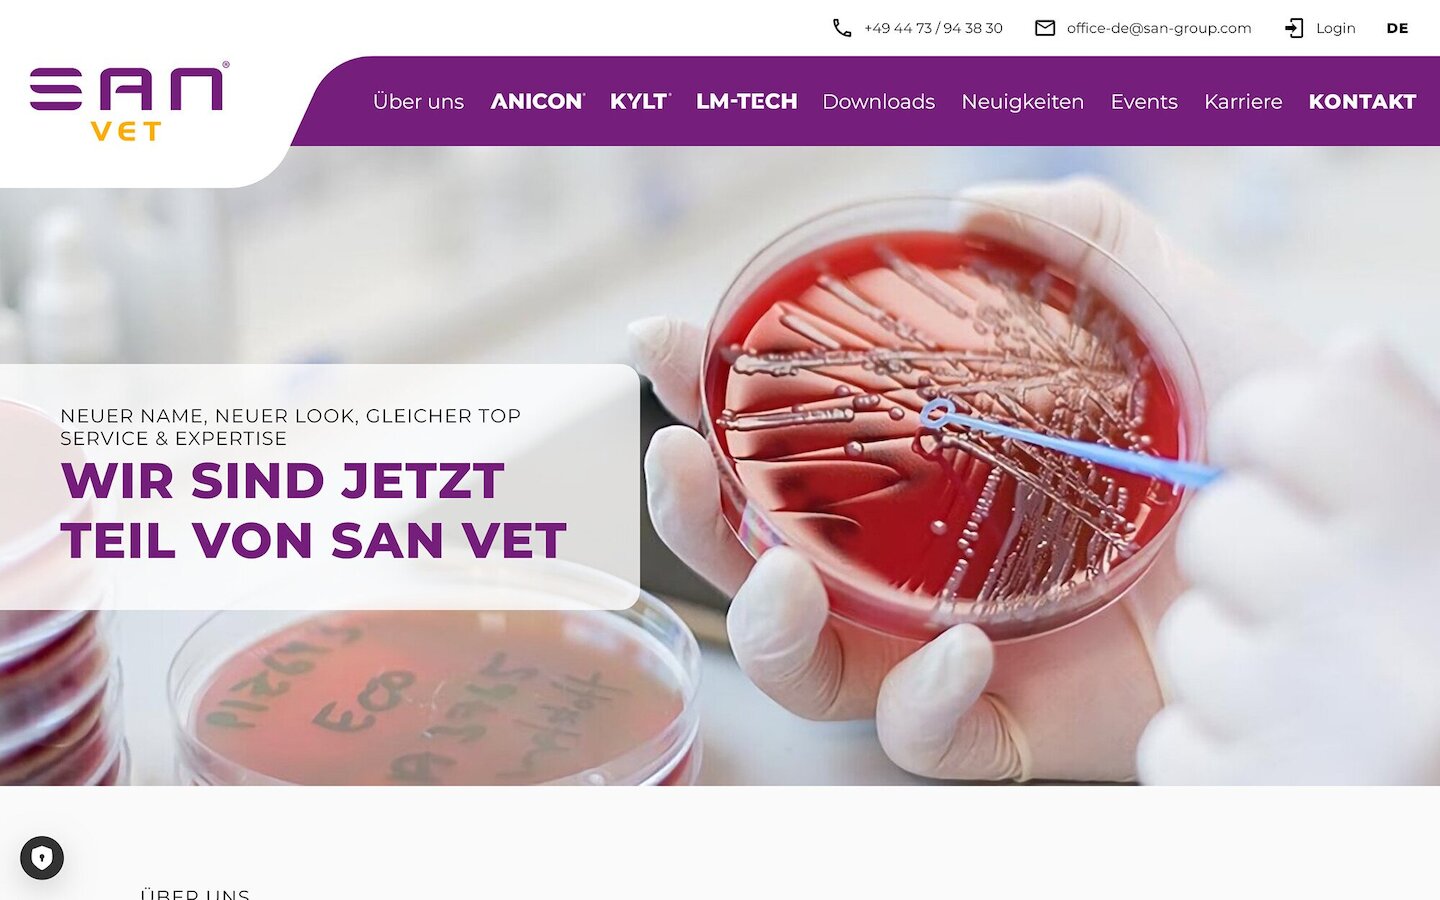
Desktop Screenshot der Website von: SAN Vet

SAN Vet

Nach der Übernahme des AniCon Labors durch die SAN Group Biotech Germany GmbH ist nun endlich die neue und vollständig überarbeitete Webseite online. Angelehnt wurde das neue Design an die CI der SAN Group.
Die SAN Vet aus Höltinghausen ist ein Dienstleister für kundenorientierte Lösungen in den Bereichen der Veterinärdiagnostik, Produktion bestandspezifischer Impfstoffe und Lebensmittelsicherheit.
Die neue zweisprachige Webseite wurde von Grund auf neu konzipiert und macht auch auf mobilen Endgeräten eine gute Figur. Sie ist übersichtlich und grafisch sehr ansprechend.
Kunden des weltweit bekannten, modernen Laborzentrums können sich hier umfassend über Untersuchungsmöglichkeiten für die Tierarten Rind, Schwein, Geflügel und Fisch informieren und wichtige Formulare hier downloaden.